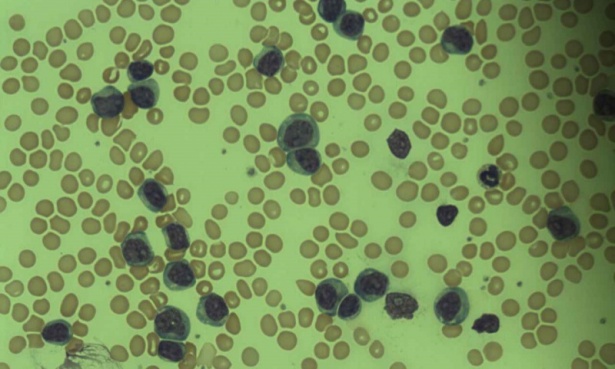

Друга лимфоидна левкемия МКБ C91.7
Злокачествените кръвни заболявания представляват диспластични процеси, с произход от клетките на миелопоезата в костния мозък и клетките на лимфопоезата в лимфните тъкани.
Друга лимфоидна левкемия е нехочкинов лимфом, дължащ се на патологични отклонения обикновено в Т клетките, много рядко В клетките.
По своята същност, начин на възникване, морфологична и функционална характеристика и развитие е почти напълно сходен с останалите лимфоидни левкемии.
Факторите, причиняващи развитието на това състояние не са ясни, но някои ендогенни и екзогенни въздействия могат да имат отношение, като например генетична предиспозиция, някои автоимунни и възпалителни заболявания, наследствен или придобит имунен дефицит, вредности от околната среда, йонизираща радиация, продължителна употреба на някои медикаменти и други.
Характеризира се с ниска честота, относително бавно развитие и еволюция. Среща се по-често във възрастта след 50 години, без съществени различия в засягането между двата пола.
Възможно е дълго безсимптомно развитие и откриване на състоянието при провеждане на изследвания по друг повод. Обикновено са налице някои от следните общи признаци:
- отпадналост и лесна уморяемост
- намален апетит
- редукция на телесната маса
- нощни изпотявания
- увеличени лимфни възли
- органомегалия
Рядко се наблюдава засягане и на кожата и поява на обриви, сърбеж, нарушение на целостта на кожата.
Диагнозата при друга лимфоидна левкемия се поставя след извършване на редица изследвания. Физикалният преглед и данните, получени от пациента, рядко са информативни и насочващи към конкретно заболяване. Промените в кръвната картина са характерни за лимфоидните левкемии. Образните изследвания с висока разделителна способност дават информация за локализацията и степента на засягане на съответните структури.
С най-голяма информативна стойност и за потвърждаване на диагнозата се извършва биопсия на засегнатите структури и на костен мозък и последващо изследване на получения материал под микроскоп и определяне на хистологичните особености.
Лечението се състои в провеждане на химиотерапветични курсове и продължително активно проследяване на пациентите. За предпочитане е комбинираната полихимиотерапия, която показва значително по-добри резултати от монотерапията. При някои от болните се прилага и хирургично лечение, състоящо се в отстраняване на засегнатите структури.
При тежко и агресивно протичащи форми е необходимо прибавяне на моноклонални антитела и интерферони към химиотерапевтиците.
Заглавно изображение: Osaretin, CC BY-SA 4.0, via Wikimedia Commons
Симптоми и признаци при Друга лимфоидна левкемия МКБ C91.7
- Повишена телесна температура
- Загуба на тегло
- Увеличен черен дроб
- Увеличен далак
- Нощно изпотяване
- Подути лимфни възли
Коментари към Друга лимфоидна левкемия МКБ C91.7